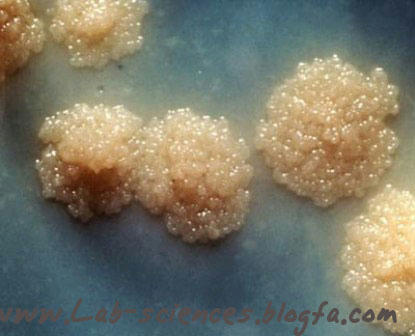
کلنی های باسیل سل بر روی محیط کشت لوین اشتاین جانسون

سل ریوی
بیماری سل ریوی یکی از مهمترین و خطرناکترین بیماری ها مربوط به ریه ها می باشد.در بیماری سل ریوی بافت درگیر ریه های فرد است. علائمی که معمولا در فرد مبتلا به سل ریوی دیده می شوند عبارتند از: کاهش وزن ، سرفه بیش ازدو هفته ، دفع خلط همراه با خون و تب نه چندان بالا.
-

-
بیماری سل ریوی معمولا از طریق تنفس مستقیم منتقل می شود. معمولا عدمرعایت فاصله یک متری بین عامل بیماری و یا فرد بیمار با افراد سالم می تواند باسیل را سرایت دهد .
مراحل تشخیصی بیماری سل به شرح زیر می باشد:
۱ ) بررسی علائم بالینی بیمار
اولین مرحله در تشخیص بیماری سل بررسی علائم ظاهری و بالینی به همراه تست فیزیکی بیمار می باشد این بررسی باید توسط پزشک متخصص انجام شود.
۲ ) عکس رادیوگرافی
در صورتی که فرد بیمار علائمی مشکوک به بیماری سل داشته باشد پزشک از فرد عکس رادیوگرافی از ریه ها را درخواست می کند .

۳ ) تست PPD
PPD پروتئین خالص شده مایکو باکتریوم توبرکولوزیس در محیط مایع می باشد.برای تشخیص اینکه آیا فرد با باسیل سل آلوده شده است یا نه از این تست استفاده می شود .

برای انجام این تست مقدار مشخصی از انتی ژن را به صورت داخل جلدی به فرد مشکوک (از ساعد ) ترزیق می کنیم و بعد از سه روز قطر ناحیه حساس شده را با خط کش اندازه گیری می کنیم . نتایج به شرح زیر تفسیر می شود :
-
اگر مقدار آن بیشتر از 15 میلی متر باشد در این صورت تست PPD فرد مثبت گزارش می شود .
-
اگر مقدار آن بین 10 تا 15 میلی متر باشد در افرادی که سابقه تماس با باسیل سل را داشته اند مثبت گزارش می شود .
-
اگرمقدار آن کمتر از 10 میلی متر باشد در این صورت جواب تست PPD منفی است .
نکته : اگر تست PPD مثبت باشد دلیل بر آلودگی فرد با باکتری است نه بیماری فرد .
۴ ) انجام آزمایشات اختصاصی
چون باسیل سل به راحتی می تواند افراد را آلوده کند بنابراین انجام آزمایشات اختصاصی باید در آزمایشگاه های کاملا پیشرفته و اختصاصی انجام شود .
با توجه به اینکه باسیل سل بعد از مدتی ممکن است بسیاری از بافتهای بدن را آلوده کند بنابراین نمونه هایی که به آزمایشگاه سل و ریوی فرستاده می شوند از تنوع بسیار زیادی برخوردار هستند. اما اولین و بیشترین نمونه ای که از بیمار برای تخلیص باسیل سل ریوی در خواست می شود نمونه خلط است .
نمونه گیری خلط
اولین مرحله در انجام آزمایشات اختصاصی ، نمونه گیری می باشد . در این مرحله از فرد بیمار نمونه خلط به روش های مختلفی تهیه می شود که به شرح زیر می باشد :
-
نمونه گیری استاندارد
نمونه گیری استاندارد خلط شامل سه مرحله نمونه گیری به شرح زیر می باشد :
-
در بدو ورود به آزمایشگاه(روز اول)
-
روز دوم (صبح گاهی)
-
دو ساعت بعد از نمونه دوم
اگر نمونه گیری در یکی از مراحل فوق با مشکل مواجه شود و فرد نتواند نمونه بدهد در این صورت سه نمونه در عرض سه روز از فرد درخواست می کنیم . (هر روز یک نمونه)
-
نمونه گیری به روش القایی(نبولایزر)
در برخی از موارد که فرد بیمار نمی تواند به شیوه استاندارد و معمولی نمونه خلط بدهد می توان از روش القایی برای نمونه گیری استفاده کرد . روش القایی معمولا در اتاقک خاصی با کمک دستگاهی به نام نبولایزر انجام می شود .
اساس کار این دستگاه بر مبنای استفاده از امواج فرا صوت می باشد .دردستگاه نبولایزرمحفظه ای وجود دارد که در آن NACL 5 تا 10 درصد ریخته می شود . این مخلوط آب و نمک توسط امواج فرا صوت به حالت تبخیر در آمده و از طریق خرطومی که فرد بیمار از آن تنفس می کند وارد ریه های فرد شده و باعث تحریک آنها می شود .
-
بعد از استفاده از خرطومی باید آن را استریل کنیم اما چون نمی توانیم آن را اتوکلاو کنیم بنابراین در ظرف گلوتارالدهید قرار می دهیم.
-
گولوتارالدهید به میزان 15 سی سی به عنوان فعال کننده عمل می کند اما اگر میزان ان یک لیتر باشد به عنوان ضد عفونی کننده استفاده می کنیم .
-
بعد از استفاده از اتاق نبولایزر لامپ های UVرا برای استریل کردن اتاقک به مدت یک ساعت روشن می کنیم .
-
شستشوی معده
اگر از فرد بیمار نتوان به روش القایی هم نمونه تهیه کرد از شستشوی معده استفاده می کنیم .این مرحله معمولا در بیمارستان انجام شده و محتویات معده در ان مورد برسی قرار می گیرد .
-
شستشوی برونش
اگر نتوان از فرد به روش های فوق نمونه گیری کرد باید از روش شستشوی برونش یا برونکوسکوپی استفاده کرد . این روش توسط پزشک انجام می شود .
مقدار خلط
مقدار استاندارد نمونه خلط باید بین 2 الی 5 سی سی باشد . در صورتی که میزان نمونه دریافت شده کم باشد کلیه تست های اختصاصی را انجام می دهیم اما درگزارش به ناکافی بودن نمونه باید اشاره کنیم . نمونه ها باید در ظروف کاملا استریل و شفاف جمع اوری شده باشند تا بتوان آنها را از نظر کمیت و کیفیت مورد بررسی قرار داد .در گزارش جواب باید به کمیت و کیفیت نمونه ها اشاره کنیم .
نمونه های جایگزین
اگر با توجه به شرایط استانداری که در بالا ذکر کردیم نتوانیم از فرد نمونه خلط دریافت کنیم ، در این صورت باید از فرد سایر نمونه ها را درخواست کنیم . سایر نمونه ها باید توسط دستگاه های خاص و یا توسط پزشک متخصص جمع اوری شود .
انجام آزمایشات اختصاصی بر روی نمونه دریافتی مشکوک به سل
پذیرش
پس از انتقال نمونه ها به آزمایشگاه ابتدا مشخصات فرد بیمار(نام ، نام خانوادگی و... ) و مشخصات نمونه(نوع نمونه ، کمیت و کیفیت آن و...) را در دفاتر مخصوصی وارد می کنند. سپس آزمایشات اختصاصی را بر روی نمونه ها انجام می دهند
هموژنیزاسیون
نمونه خلط و یا سایر نمونه هایی که از مریض گرفته می شوند معمولا دارای فلور نرمال بدن، قارچ ها و سایر باکتری ها می باشند که باید برای برسی نمونه ها از نظر باسیل سل آنها را ایزوله کنیم بطوریکه فقط مایکو باکتریوم ها باقی بمانند . برای این کار از روشی به نام پتروف استفاده می کنیم که به شرح زیر می باشد:
روش پتروف
در این متد برای از بین بردن سایر باکتری ها و فلور نرمال از NAOH 4 درصد(یک نرمال) استفاده می کنیم.کلیه عوامل خارجی در NAOHیک نرمال در مدت زمان یک ساعت از بین می روند به غیر از باسیل های سل (به علت داشتن دیواره لیپیدی )
برای انجام این متد ابتدا به نمونه ها هم حجم یا دو برابر حجم نمونه NAOH 4 درصد (یک نرمال) اضافه می کنیم . بعد از ریختن NAOH باید نمونه ها را به لوله های فالکون منتقل کرده و به مدت 1 ساعت روی دستگاه میکسر قرار بدهیم(برای مخلوط شدن نمونه ها) سپس به مدت 25 الی 30 دقیقه نمونه ها را در روی شیکر قرار می دهیم . بعد از مدت فوق نمونه ها را وزن کرده و سپس به مدت 30 – 20 دقیقه در دور RPM3000 سانتریفیوژ می کنیم . بعد از سانتریفیوژ نمونه ها، مایع فوقانی رسوب را تخلیه می کنیم به طوری که فقط رسوب باقی بماند .
-
از اسید اگزالیک 5 درصد هم می توان برای گند زدایی استفاده کرد .
خنثی سازی در آزمایشگاه سل
به علت اینکه برای ایزوله کردن نمونه ها از NAOH استفاده می کنیم بنابراین رسوب بدست آمده قلیایی خواهد بود که برای رشد بهتر باکتری ها باید این محیط قلیایی ، خنثی شود برای این کار از روشی به نام "خنثی سازی " استفاده می کنیم .
در این روش ابتدا یک قطر فنول فتالئین یک درصد به عنوان معرف به رسوب اضافه می کنیم این معرف در PH بازی به رنگ ارغوانی ، درPH اسیدی به بیرنگ و در PH خنثی به رنگ قرمز گلی تغییر رنگ می دهد . پس از ریختن معرف ، HCl یک نرمال(3.2 درصد) را به صورت قطره قطره به نمونه اضافه می کنیم تا جایی که رنگ نمونه از ارغوانی به بیرنگ تغییر کند .
کشت باسیل سل
بعد از خنثی سازی باید نمونه ها را در یک محیط اختصاصی به نام لوین اشتاین جانسون کشت بدهیم بدین ترتیب که مقداری از رسوب (4 قطره)را به 6 الی 8 سی سی محیط کشت اضافه می کنیم بعد از انتقال نمونه ها به محیط کشت باید مقداری از درپوش لوله ها(مک کارتنی) را باز نگه داریم تا رطوبت اضافی از ان خارج شود سپس آنها را به اتاق گرم خانه(38 – 37 درجه سانتیگراد) منتقل می کنیم و بعد از 4 روز در پوش محیط های کشت را محکم می بندیم . محیط های کشت هفته ای دو بار کنترل می شوند بدین ترتیب که یک بار کل گرمخانه و یک بار هم بصورت سریع رشد را بررسی می کنیم .اگر رشدی در محیط های کشت مشاهده نشد آنها را به مدت 2 ماه در گرمخانه نگهداری می کنیم .
نکته بسیار مهم : همان طور که گفتیم ، باسیل سل از طریق آئورسل ها با شدت تمام انتقال میابد بنابراین در تمام این مراحل استفاده از وسائل ایمنی شامل ماسک های ویژه ، لباس مخصوص ، عینک ، دستکش لاتکس و از همه مهتر کار در زیر هود های تیپ ۲ انجام گیرد . در غیر این صورت..... خودتون میدونید دیگه .